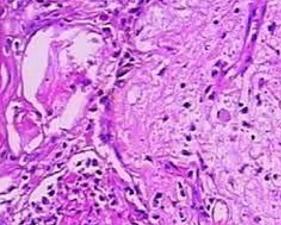

恶性萎缩性丘疹病 又称Dego病、Kohlmeier-Degos综合征,致死性皮肤和胃肠道细动脉血栓形成(lethal cutaneous and gastrointestinal arteriolar thrombosis)。本病是皮肤-肠道或其他器官的细小动脉内膜炎而后血栓形成的疾病,病因还不明,有认为与常染色体显性遗传、自身免疫异常和纤溶活性降低及慢病毒感染等有关以青壮年男性发病率最高,约1/3病例只有皮肤损害约20%病例累及中枢神经系统少见的尚可累及眼心、肾和膀胱等。IgA可显著升高。需与淋巴瘤样丘疹病、急性痘疮样苔藓样糠疹和变应性皮肤血管炎相鉴别。目前主要是对症治疗。
恶性萎缩性丘疹病 又称Dego病、Kohlmeier-Degos综合征,致死性皮肤和胃肠道细动脉血栓形成(lethal cutaneous and gastrointestinal arteriolar thrombosis)。本病是皮肤-肠道或其他器官的细小动脉内膜炎而后血栓形成的疾病,病因还不明,有认为与常染色体显性遗传、自身免疫异常和纤溶活性降低及慢病毒感染等有关以青壮年男性发病率最高,约1/3病例只有皮肤损害约20%病例累及中枢神经系统少见的尚可累及眼心、肾和膀胱等。IgA可显著升高。需与淋巴瘤样丘疹病、急性痘疮样苔藓样糠疹和变应性皮肤血管炎相鉴别。目前主要是对症治疗。